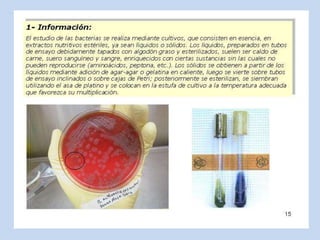

Incrustar presentación
Descargar para leer sin conexión









































El documento clasifica los microorganismos en dos grupos: 1) microorganismos con organización celular como procariotas, arqueobacterias, eubacterias, protozoos y algas microscópicas, hongos microscópicos; y 2) microorganismos sin organización celular como virus, viroides y priones que son parásitos de los organismos celulares. Dentro de los procariotas se clasifican las bacterias en aerobias, anaerobias y facultativas.